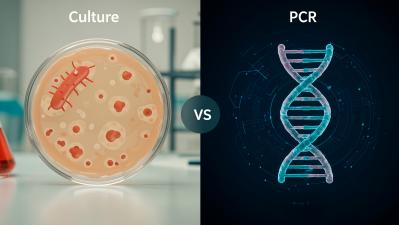

Culture vs. PCR Testing for Legionella: Which Detective Should You Hire?
You've done the hard work of setting up your Water Management Plan. Now, it’s time for a critical step: testing your water to see what’s actually going on in there. But when you look at testing options, you might see terms like "Culture" and "PCR."
So, what’s the difference? Think of it like hiring two different types of detectives to solve the same case. Both are excellent, but they have different skills and give you different types of intel. Choosing the right one depends on what question you’re trying to answer.
The Seasoned Detective: The Culture Method
The culture method is the classic, time-tested gumshoe of Legionella testing.
- How it works: We take your water sample, put it on a special growth medium (think of it as a steak dinner for bacteria), and wait to see if any Legionella colonies grow. If they do, we can count them. This method specifically looks for living bacteria that are viable and capable of causing infection.
- What it tells you: It gives you a quantifiable result of living bacteria, often in Colony-Forming Units (CFU). This is the "gold standard" recognized by the CDC and is often required for regulatory compliance.
- The Catch: Like any good detective work, it takes time. Results can take 7-14 days because we have to give the bacteria time to grow.
You'd hire this detective when you need to know not just if Legionella is there, but if it's alive and kicking, and in what numbers—crucial for assessing immediate health risk.
The High-Tech Profiler: The PCR Method
PCR (Polymerase Chain Reaction) is the high-tech, DNA-profiling detective.
- How it works: Instead of growing the bacteria, PCR looks for Legionella's genetic fingerprint (its DNA). It’s incredibly sensitive and can detect the DNA of both living and dead bacteria.
- What it tells you: It gives you a rapid "yes" or "no" answer on the presence of Legionella DNA. Because it's so fast, it's an amazing tool for quick screening or confirming the presence of the bacteria after a disinfection process (when you'd expect to find dead bacteria).
- The Catch: A positive PCR result doesn't necessarily mean you have a live, infectious threat, since it detects DNA from dead cells too.
You'd hire this detective when speed is critical, you need to quickly screen a system, or you want to verify that a cleaning was effective.
So, Which One Is Right for You?
Honestly? Sometimes, you need both. Many effective Water Management Plans use a combination: PCR for quick checks and monitoring, and Culture for baseline risk assessment and compliance.
The best strategy depends on your facility, your industry's regulations, and your specific goals. You don’t have to be the expert on this—that’s what we’re here for.
Get Expert Guidance on Your Testing Strategy
Choosing the right testing method is a key part of responsible facility management. Understanding your options empowers you to make smarter, safer decisions.
Want to learn more about how to evaluate a testing lab's capabilities?
Download our FREE "Protecting Your Facility: A Guide to Legionella Prevention & Choosing the Right Testing Lab" to help you ask the right questions.